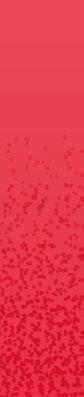

Projets seléctionnés
Corentin Bonnet
Exposition "Créer sous Louis XIV" au Mobilier National
Photographie Stéphane Sby Balmy / Photogravure S.A Résolution Direction artistique Studio Axiome
Table en pierres dures, musée du Louvre, Département des Objets d’art. ©

Les manufactures de la Couronne sous Colbert et Le Brun
Galerie des Gobelins 18 septembre –4 décembre 2019
Carte blanche à Mathias Kiss Chapelle des Gobelins
Galerie des Gobelins 42 av. des Gobelins - Paris 13 mobiliernational.culture.gouv.fr
#ModerneDepuisDesLustres



Affiche
Déclinaison en kakémonos
Exposition
"Créer sous Louis XIV" au Mobilier National

Affiche
Événement Le Louvre "Secret d’Arcadie"


Déclinaison sur bâche
Événement Le Louvre "Secret d’Arcadie"


Affiche
Événement Le Louvre "Secret d’Arcadie"

LE GRAND JEU DE L’ÉTÉ AU JARDIN DES TUILERIES

Du 10 juillet au 30 août 2021
Cahier d’activités pour enfants
Campagne TotalEnergie CAN 2021
SEEK & FIND
Try to find as quickly as possible the elements hidden in this picture. No. 1
SEEK & FIND
Try to find as quickly as possible the elements hidden in this picture. No. 2

Cahier d’activités pour enfants
Campagne TotalEnergie CAN 2021
ADD SOME COLOURS!
ADD SOME COLOURS!
No. 5
No. 7

Proposition de couverture
Rapport d’activité 2020 HP-HF

FONDS D’AIDE D’URGENCE COVID-19
- RAPPORT D’ACTIVITÉ 2020 -
Proposition de couverture
Rapport d’activité 2020 HP-HF

LE FONDS D’AIDE D’URGENCE COVID-19 EN BREF

Proposition de couverture
Rapport d’activité 2020 HP-HF


UNE ACTION CIBLÉE TOUCHANT L’ENSEMBLE DU TERRITOIRE
Proposition de couverture
Rapport d’activité 2020 HP-HF

COMPRENDRE L’ACTION DE LA FONDATION
PENDANT LA CRISE


L’ENSEMBLE DU TERRITOIRE FRANÇAIS EN
CRISE
Aucune région, ni aucun département n’a été épargné par la crise du Covid-19 et par son impact sur les familles et les proches des malades, mais aussi sur le personnel des établissements de santé confrontés à la violence de l’épidémie et aux nombreux décès. Pendant cette période douloureuse, la Fondation des Hôpitaux s’est attachée à répondre, à son niveau, aux besoins exprimés par les hôpitaux et des EHPAD afin de les soutenir dans leurs efforts de réorganisation et de lutte contre le virus.


CHRONOLOGIE DE LA GESTION DE CRISE

16 Mars Création du Fonds d’Aide d’urgence Covid-19 de la Fondation Hôpitaux de Paris-Hôpitaux de France pour soutenir les hôpitaux et les EHPAD confrontés à la crise sanitaire.
17 Mars Début du confinement en France. Appel aux soignants pour faire remonter les besoins les plus urgents principalement des personnels de santé, des patients et de leurs familles.
24 Mars Adoption de la loi déclarant l’Etat d’urgence sanitaire
?? Mars Phase 1 de soutien aux hôpitaux les plus touchés par l’épidémie signalés par la Fédération Hospitalière de France.
Dans le même temps, un plan d’aide aux EHPAD est mis en œuvre dans le but de limiter l’impact de l’isolement lié au confinement sur les personnes âgées.
22 Avril Phase 2 du soutien aux hôpitaux. Les centres hospitaliers ayant accueillis des transferts de patients Covid-19 sont ciblés, ainsi que les Centre Hospitaliers en Santé Mentale, durement impactés par le confinement
11 Mai Début du déconfinement en France.
?? Juin Phase 3 de financement pour faire face aux nouveaux enjeux apparus avec la fin du confinement. Le soutien au rapprochement des familles dans les EHPAD est renforcé.
La Fondation lance un plan de soutien pour offrir des solutions de répit pendant l’été aux aidants d’enfants atteints de handicap ou de maladies chroniques et privés des structures d’accueil habituelles fermées pendant le confinement. Carte des actions financées par la Fondation des Hôpitaux pendant la crise
Le Fonds d’aide d’urgence Covid-19 en bref 4
Rapport d’activivité 2020 5
d’activité 2020
Proposition de couverture Rapport
HP-HF
Proposition de couverture
Rapport d’activité 2020 HP-HF

PLAN D’AIDE D’URGENCE COVID-19
La Fondation Hôpitaux de Paris-Hôpitaux de France s’est donnée pour objectifs d’améliorer la prise en charge des patients et les conditions de travail des soignants à l’hôpital tout en organisant le déploiement de nombreuses aides aux EHPAD.

PHASE 1 EN PREMIÈRE LIGNE DÈS LE DÉBUT DE LA CRISE AIGUË
L’appel lancé aux directeurs et aux équipes des hôpitaux et EHPAD pour faire remonter les besoins les plus urgents a permis à la Fondation de mettre en place une aide structurée pour toucher les établissements les plus fragilisés et apporter un soutien aux soignants, aux patients et à leurs familles.
Cet engagement s’est traduit par un plan national d’aide aux hôpitaux et aux EHPAD dont la mise en œuvre s’est maintenue pendant toute la période de confinement , puis pendant les mois d’été afin d’accompagner la période post-crise aiguë
Trois phases successives de financement ont permis une gestion de crise s’adaptant semaine après semaine à l’ évolution des besoins du secteur hospitalier et des EHPAD.
Phase 1
Phase 2 Phase 3
Se placer en première ligne dès le début de la crise aiguë
Absorber l’impact du confinement en période de crise aiguë

Accompagner le contrecoup du déconfinement en période post-crise
Axe n°1 : Soutenir la réorganisation accélérée des hôpitaux et des EHPAD
La Fondation a apporté un soutien financier d’un peu plus de 10 millions d’euros ciblant 57 hôpitaux en première ligne afin de leur permettre d’étendre leur capacité d’accueil et de s’adapter à la prise en charge de l’afflux de malades touchés par le coronavirus.
Une aide de 5 millions d’euros a également été débloquée à destination de plus de 3000 EHPAD sur l’ensemble du territoire.
Axe n°2 : Protéger les soignants et alléger leur quotidien
La Fondation a permis de financer du matériel de protection pour assurer la sécurité des soignants contre le coronavirus (masques, lunettes de protection, charlottes, surblouses, sur-chaussures, gants... etc.).
La livraison de repas chauds directement dans les services, la prise en charge des frais de transport des soignants ou encore d’hébergement à proximité de l’hôpital ainsi que le financement de solutions de garde pour leurs enfants ont également été une priorité pour la Fondation afin d’alléger le quotidien des soignants bouleversé par la surcharge d’activité.
Axe n°3 : Maintenir le lien familial des patients et des personnes âgées confinés avec leurs proches
Les malades dans les services de réanimation et les personnes âgées dans les EHPAD ont été les premiers touchés par l’éloignement physique imposé par le confinement. Pour lutter contre leur isolement la Fondation a financé du petit matériel numérique (tablettes, webcam, enceintes, … etc.) ou encore des cadres numériques pour recevoir des photos et des messages de leur famille en direct.
Le Fonds d’aide d’urgence Covid-19 en bref 7
Rapport d’activivité 2020
6
Coeur de ville en Lumières
 Mapping "IGNI"
Mapping "IGNI"

Temps Mort

Paysage

Le hérisson

 L'astronaute
L'astronaute

 L'astronaute
L'astronaute
corentinbonnet@live.fr Corentin Bonnet 06.87.16.73.61 Mel : Tel :

Mapping "IGNI"
Mapping "IGNI"




 L'astronaute
L'astronaute

 L'astronaute
L'astronaute